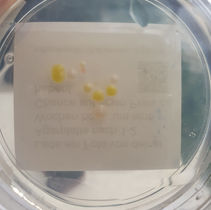
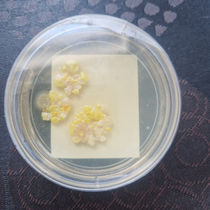

top of page
Vielen Dank, dass Sie uns in der Langen Nacht der Wissenschaften besucht haben!
Thank you for visiting us during the Long Night of Science!
Hier kannst du ein Foto deines Agarabdrucks hochladen.
You can upload a photograph of your agar print here.
Die drei Bilder mit den meisten Likes gewinnen einen Preis (❤️)
3 of the most liked images will win a prize (❤️)
Die Bilder werden unten in einer Galerie veröffentlicht (dies geschieht nicht automatisch -
schauen Sie wöchentlich nach Updates!)
Images will be posted in a gallery below (This does not happen automatically--check back weekly for updates!)
Agar Gallery LNDW 2024
Agar Gallery LNDW 2023
bottom of page